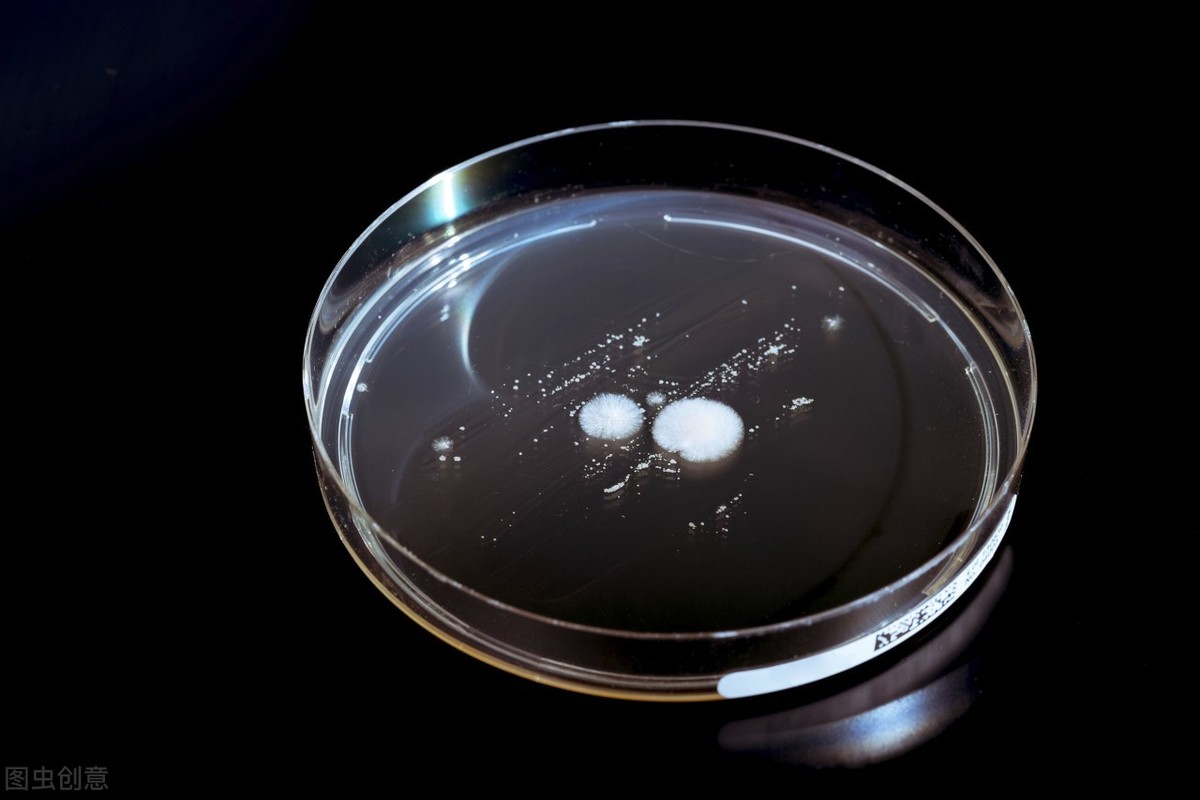

登陸火星這是未來我們很快會實現的壯舉,有生之年也許我們會看到這一幕。但在此之前我們需要解決一些問題。
很明顯登陸火星這件事已經喊了很多年,但一直沒有行動。原因在於目前依舊有一些難題困擾著我們。

跟登陸月球不同的是,月球離我們非常近,是最近的天體,平均距離大約38萬公里,出去旅行一圈大約7到8天的時間足以。
例如阿波羅11號是在1969年7月16日出發,於7月24日濺落在太平洋,任務期間在月球上總共待了兩個多小時,時間太長會對宇航員的健康產生威脅。

可以看出月球任務時間非常短,除此之外還有返回的問題,月球的引力約為地球1/6,著陸艙從月球表面起飛相對容易,攜帶的燃料較少。
但登陸火星要複雜的多。你看,火星距離地球最近5500萬公里,從距離上來說是月球的145倍,單程前往火星至少需要7到8個月的時間,來回這得最少一年多。

而且到了火星也不可能像登陸月球一樣,短短的兩個小時就返回是不現實的,不然這錢花得也太不值了。任務週期的增長就大大增加了了宇航員在外太空暴露的時間。
現在的宇航服雖然可以給宇航員提供生命支持,隔絕真空或者有毒氣體,但是目前依舊沒有解決宇宙輻射粒子侵害的難題。

由於火星大氣層稀薄而且沒有磁場,因此火星上會存在大量的有害射線。這就是目前困擾我們登陸火星最大的難題。
其次就是返回的問題,火星引力是地球的38%,差不多比月球引力高一倍,且距離非常遙遠,這就要攜帶更多的燃料,以及宇航員生命支持的物品,重量就增加了很多。
以上兩個問題就是我們未來去往火星的難題。但最近一項新的研究很有可能解決其中一個最為關鍵的問題,就是宇航員的輻射問題。

這項研究2020年7月17日發表在《bioRxiv》雜誌上,標題為《用於人類深空探索的自我複製輻射防護罩:輻射營養真菌可以衰減國際空間站上的電離輻射》(A Self-Replicating Radiation-Shield for Human Deep-Space Exploration: Radiotrophic Fungi can Attenuate Ionizing Radiation aboard the International Space Station)
這篇論文目前是預印本,還沒有經過同行評審的認證,論文指出科學家在切爾諾貝利反應堆的牆上發現了一種真菌,可以為未來人類登陸火星提供幫助。

1986年,烏克蘭境內切爾諾貝利核電站事故是人類有史以來最為嚴重的核汙染事故,瞬間方圓數百公里土地、大氣沈浸在了過量放射性的侵害之中。
人類撤離並封鎖了該地區,但這個地方依舊生活著其他生物,在事故發生的前幾年這裡的生物數量明顯降低,但目前來看所有的生物又重新佔據了這個地方,並且在物種多樣性和數量上都有所回升。

這次事故讓人類第一次覺得生物在面對核輻射時所表現出的頑強,2020年2月研究人員在切爾諾貝利核電站的核反應堆的牆壁上發現了一種黴菌,是球孢枝孢黴(Cladosporium sphaerospermum)的一種。
這種黴菌含有大量的黑色素,不僅能在致命的放射水平中生存,還能茁壯成長,更加神奇的是,這種真菌能夠吸收放射線將其轉換成自身所需要的化學能量。
科學家如何知道這件事的?
首先在切爾諾貝利發現這種真菌科學家就懷疑它已經經過變異能夠抵擋輻射。所以就決定對這種真菌進行研究。
在宇宙空間,不僅有高能量的宇宙射線,更多的太陽風粒子,這些粒子攜帶非常高的能量,在整個空間中自由的穿梭,即使宇航員待在國際中間站內每天就會接受到0.5 ~ 1毫西弗的輻射劑量。

所以未來人類想要走出地球,必須克服放射性對自身的危害。因此NASA一直都在研究如何讓宇航員免受太空輻射的方法,這種真菌的發現,就提供了一種可能。
在NASA的協助下,科學家將在切爾諾貝利發現的黴菌的樣品帶到了國際空間站。然後在背面安裝有放射性檢測儀器的容器內,一半塗上這種真菌,一般不塗進行了30天的觀測比較。

上圖中的A到I是以6小時為間隔進行拍攝,左邊塗了真菌。可以看出這種真菌在微重力環境下僅僅48小時就繁殖到覆蓋了一半的容器。
實驗結果表明,塗有真菌的背面放射性減少了2%,因此研究小組推測,這些真菌可以利用放射性的能量來進行更加快速的繁殖,而且比地面上生長的速度更快。
進行實驗的NASA科學家Kasthuri Venkateswaran表示,這種真菌可以作為宇航員防輻射的“防曬霜”使用。

雖然減少了輻射減少了2%看起來不多,這不足以保護宇航員,但是容器中的真菌厚度只有2mm,研究人員認為,如果有21釐米厚,將能夠抵擋火星上大部分的輻射,在火星上待一年時間都不成問題。
這種真菌會自行生長,這意味著我們只需攜帶少量的真菌。一旦達到火星,真菌可以在一個保護層上培育,讓它變得稠密,為宇航員提供一層防輻射保護。
NASA計畫在2024年重返月球,還有火星登陸計畫,未來還要月球火星建立基地,因此這項研究應用的可能性非常值得期待。









